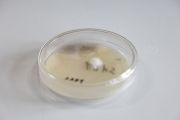

This special page shows all uploaded files.
| Date | Name | Thumbnail | Size | Description | Versions |
|---|---|---|---|---|---|
| 22:50, 29 November 2017 | 1590301.jpg (file) |  |
6.7 MB | File uploaded with MsUpload | 1 |
| 22:59, 29 November 2017 | 1590296.jpg (file) |  |
6.77 MB | File uploaded with MsUpload | 1 |
| 23:01, 29 November 2017 | 1590297.jpg (file) |  |
7.24 MB | File uploaded with MsUpload | 1 |
| 23:05, 29 November 2017 | 1590300.jpg (file) |  |
6.83 MB | File uploaded with MsUpload | 1 |
| 15:16, 9 December 2017 | Sendarduino inputs viaosc.pd (file) | 2 KB | File uploaded with MsUpload | 1 | |
| 15:48, 9 December 2017 | Sendarduino inputs viaosc and select.pd (file) | 2 KB | 2 | ||
| 22:27, 9 December 2017 | Stirrer.MOV (file) | 3.02 MB | File uploaded with MsUpload | 1 | |
| 12:17, 14 December 2017 | G2running.jpg (file) |  |
2.27 MB | File uploaded with MsUpload | 1 |
| 23:59, 14 December 2017 | Fungal-pet.jpg (file) |  |
2.8 MB | File uploaded with MsUpload | 1 |
| 12:56, 19 December 2017 | FlyingElephantTrap.jpg (file) |  |
7.99 MB | File uploaded with MsUpload | 1 |
| 01:01, 16 February 2018 | 2018 02 07 0002.JPG (file) |  |
2.98 MB | File uploaded with MsUpload | 1 |
| 01:01, 16 February 2018 | 2018 02 07 0003.JPG (file) |  |
3.23 MB | File uploaded with MsUpload | 1 |
| 01:02, 16 February 2018 | 2018 02 07 0004.JPG (file) |  |
3.2 MB | File uploaded with MsUpload | 1 |
| 01:02, 16 February 2018 | 2018 02 07 0005.JPG (file) |  |
3.42 MB | File uploaded with MsUpload | 1 |
| 01:03, 16 February 2018 | 2018 02 07 0006.JPG (file) |  |
3.35 MB | File uploaded with MsUpload | 1 |
| 01:03, 16 February 2018 | 2018 02 07 0007.JPG (file) |  |
3.28 MB | File uploaded with MsUpload | 1 |
| 01:04, 16 February 2018 | 2018 02 07 0008.JPG (file) |  |
3.56 MB | File uploaded with MsUpload | 1 |
| 01:05, 16 February 2018 | 2018 02 07 0009.JPG (file) |  |
3.54 MB | File uploaded with MsUpload | 1 |
| 01:05, 16 February 2018 | 2018 02 07 0010.JPG (file) |  |
3.54 MB | File uploaded with MsUpload | 1 |
| 01:06, 16 February 2018 | 2018 02 07 0011.JPG (file) |  |
3.3 MB | File uploaded with MsUpload | 1 |
| 01:06, 16 February 2018 | 2018 02 07 0012.JPG (file) |  |
3.21 MB | File uploaded with MsUpload | 1 |
| 01:07, 16 February 2018 | 2018 02 07 0013.JPG (file) |  |
3.26 MB | File uploaded with MsUpload | 1 |
| 01:07, 16 February 2018 | 2018 02 07 0014.JPG (file) |  |
3.72 MB | File uploaded with MsUpload | 1 |
| 01:08, 16 February 2018 | 2018 02 07 0015.JPG (file) |  |
3.29 MB | File uploaded with MsUpload | 1 |
| 01:08, 16 February 2018 | 2018 02 07 0016.JPG (file) |  |
3.74 MB | File uploaded with MsUpload | 1 |
| 01:09, 16 February 2018 | 2018 02 07 0017.JPG (file) |  |
3.47 MB | File uploaded with MsUpload | 1 |
| 01:10, 16 February 2018 | 2018 02 07 0018.JPG (file) |  |
4.04 MB | File uploaded with MsUpload | 1 |
| 01:23, 16 February 2018 | 2018 02 07 0001.JPG (file) |  |
3.13 MB | Reverted to version as of 01:00, 16 February 2018 (UTC) | 3 |
| 01:45, 16 February 2018 | Pleur.ostr.SAD1.JPG (file) |  |
3.23 MB | File uploaded with MsUpload | 1 |
| 01:46, 16 February 2018 | Pleur.ostr.SAD1 alternateview.JPG (file) | |
2.98 MB | File uploaded with MsUpload | 1 |
| 01:46, 16 February 2018 | Pleur.ostr.SAD2.JPG (file) |  |
3.42 MB | File uploaded with MsUpload | 1 |
| 01:47, 16 February 2018 | Pleur.ostr.SAD3.JPG (file) |  |
3.35 MB | File uploaded with MsUpload | 1 |
| 01:47, 16 February 2018 | Pleur.ostr.SAD4.JPG (file) |  |
3.28 MB | File uploaded with MsUpload | 1 |
| 01:48, 16 February 2018 | Pleur.ostr.SBD1.JPG (file) |  |
3.56 MB | File uploaded with MsUpload | 1 |
| 01:48, 16 February 2018 | Pleur.ostr.SBD2.JPG (file) |  |
3.54 MB | File uploaded with MsUpload | 1 |
| 01:49, 16 February 2018 | Pleur.ostr.SBD3.JPG (file) |  |
3.54 MB | File uploaded with MsUpload | 1 |
| 01:50, 16 February 2018 | Pleur.ostr.SBD3 alternateview.JPG (file) |  |
3.26 MB | File uploaded with MsUpload | 1 |
| 01:55, 16 February 2018 | Button E1 alternateview.JPG (file) |  |
3.29 MB | File uploaded with MsUpload | 1 |
| 01:55, 16 February 2018 | Button E2.JPG (file) |  |
3.74 MB | File uploaded with MsUpload | 1 |
| 01:56, 16 February 2018 | Button E3.JPG (file) |  |
3.47 MB | File uploaded with MsUpload | 1 |
| 11:17, 6 June 2018 | Sphere.JPG (file) |  |
1.2 MB | File uploaded with MsUpload | 1 |
| 11:25, 6 June 2018 | 0516 1.jpg (file) |  |
4.21 MB | File uploaded with MsUpload | 1 |